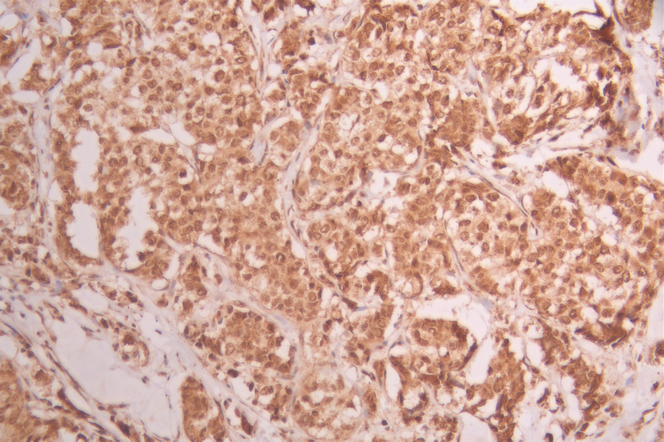

CELF1 Recombinant Monoclonal Antibody
-
中文名稱:CELF1 Recombinant Monoclonal Antibody
-
貨號(hào):CSB-RA561537A0HU
-
規(guī)格:¥1320
-
圖片:
-
Western Blot
Positive WB detected in: U-937 whole cell lysate(20μg),U-251MG whole cell lysate(20μg), SH-SY5Y whole cell lysate(20μg), A549 whole cell lysate(20μg),HepG2 whole cell lysate(20μg),NIH/3T3 whole cell lysate(20μg),Hela whole cell lysate(20μg)
All lanes: CELF 1 antibody at 1:1000
Secondary
Goat polyclonal to rabbit IgG at 1/40000 dilution
Predicted band size: 52 kDa
Observed band size: 55 kDa
Exposure time:1min20s -
IHC image of CSB-RA561537A0HU diluted at 1:100 and staining in paraffin-embedded human breast cancer performed on a Leica BondTM system. After dewaxing and hydration, antigen retrieval was mediated by high pressure in a citrate buffer (pH 6.0). Section was blocked with 10% normal goat serum 30min at RT. Then primary antibody (1% BSA) was incubated at 4°C overnight. The primary is detected by a Goat anti-rabbit polymer IgG labeled by HRP and visualized using 0.05% DAB.
-
IHC image of CSB-RA561537A0HU diluted at 1:100 and staining in paraffin-embedded human stomach tissue performed on a Leica BondTM system. After dewaxing and hydration, antigen retrieval was mediated by high pressure in a citrate buffer (pH 6.0). Section was blocked with 10% normal goat serum 30min at RT. Then primary antibody (1% BSA) was incubated at 4°C overnight. The primary is detected by a Goat anti-rabbit polymer IgG labeled by HRP and visualized using 0.05% DAB.
-
Immunofluorescence staining of Hela cell with CSB-RA561537A0HU at 1:50, counter-stained with DAPI. The cells were fixed in 4% formaldehyde, permeabilized using 0.2% Triton X-100 and blocked in 10% normal Goat Serum. The cells were then incubated with the antibody overnight at 4°C. The secondary antibody was Alexa Fluor 488-congugated AffiniPure Goat Anti-Rabbit IgG(H+L).
-
Overlay Peak curve showing Hela cells stained with CSB-RA561537A0HU (red line) at 1:100. The cells were fixed in 4% formaldehyde and permeated by 0.2% TritonX-100 for 10min. Then 10% normal goat serum to block non-specific protein-protein interactions followed by the antibody (1ug/1*106cells) for 45min at 4℃. The secondary antibody used was FITC-conjugated goat anti-rabbit IgG (H+L) at 1/200 dilution for 35min at 4℃.Control antibody (green line) was Rabbit IgG (1ug/1*106cells) used under the same conditions. Acquisition of >10,000 events was performed.
-
-
其他:
產(chǎn)品詳情
-
Uniprot No.:
-
基因名:
-
別名:50 kDa Nuclear polyadenylated RNA binding protein antibody; 50 kDa nuclear polyadenylated RNA-binding protein antibody; Bruno like 2 antibody; bruno like protein 2 antibody; Bruno-like protein 2 antibody; BRUNOL 2 antibody; BRUNOL2 antibody; CELF 1 antibody; CELF-1 antibody; celf1 antibody; CELF1 CUGBP, Elav like family member 1 antibody; CELF1_HUMAN antibody; CUG BP and ETR 3 like factor 1 antibody; CUG BP antibody; CUG BP1 antibody; CUG RNA binding protein antibody; CUG triplet repeat RNA binding protein 1 antibody; CUG triplet repeat RNA-binding protein 1 antibody; CUG-BP antibody; CUG-BP- and ETR-3-like factor 1 antibody; CUG-BP1 antibody; CUGBP 1 antibody; CUGBP and ETR3 like factor 1 antibody; CUGBP antibody; CUGBP Elav like family member 1 antibody; CUGBP Elav-like family member 1 antibody; CUGBP1 antibody; Cytidine uridine guanosine binding protein 1 antibody; Deadenylation factor CUG BP antibody; Deadenylation factor CUG-BP antibody; Deadenylation factor CUGBP antibody; EDEN BP antibody; EDEN BP homolog antibody; EDEN-BP antibody; EDEN-BP homolog antibody; embryo deadenylation element binding protein antibody; embryo deadenylation element binding protein homolog antibody; Embryo deadenylation element-binding protein homolog antibody; hNab 50 antibody; hNab50 antibody; NAB 50 antibody; NAB50 antibody; NAPOR antibody; Nuclear polyadenylated RNA binding protein 50 kD antibody; Nuclear polyadenylated RNA binding protein antibody; RNA binding protein BRUNOL 2 antibody; RNA binding protein BRUNOL2 antibody; RNA-binding protein BRUNOL-2 antibody
-
反應(yīng)種屬:Human, Mouse
-
免疫原:A synthesized peptide derived from human CELF1
-
免疫原種屬:Homo sapiens (Human)
-
標(biāo)記方式:Non-conjugated
-
克隆類型:Monoclonal
-
抗體亞型:Rabbit IgG
-
純化方式:Affinity-chromatography
-
克隆號(hào):1G2
-
濃度:It differs from different batches. Please contact us to confirm it.
-
保存緩沖液:Rabbit IgG in 10mM phosphate buffered saline , pH 7.4, 150mM sodium chloride, 0.05% BSA, 0.02% sodium azide and 50% glycerol.
-
產(chǎn)品提供形式:Liquid
-
應(yīng)用范圍:ELISA, WB, IHC, IF, FC
-
推薦稀釋比:
Application Recommended Dilution WB 1:500-1:2000 IHC 1:50-1:200 IF 1:50-1:200 FC 1:50-1:200 -
Protocols:
-
儲(chǔ)存條件:Upon receipt, store at -20°C or -80°C. Avoid repeated freeze.
-
貨期:Basically, we can dispatch the products out in 1-3 working days after receiving your orders. Delivery time maybe differs from different purchasing way or location, please kindly consult your local distributors for specific delivery time.
-
用途:For Research Use Only. Not for use in diagnostic or therapeutic procedures.
相關(guān)產(chǎn)品
靶點(diǎn)詳情
-
功能:RNA-binding protein implicated in the regulation of several post-transcriptional events. Involved in pre-mRNA alternative splicing, mRNA translation and stability. Mediates exon inclusion and/or exclusion in pre-mRNA that are subject to tissue-specific and developmentally regulated alternative splicing. Specifically activates exon 5 inclusion of cardiac isoforms of TNNT2 during heart remodeling at the juvenile to adult transition. Acts as both an activator and repressor of a pair of coregulated exons: promotes inclusion of the smooth muscle (SM) exon but exclusion of the non-muscle (NM) exon in actinin pre-mRNAs. Activates SM exon 5 inclusion by antagonizing the repressive effect of PTB. Promotes exclusion of exon 11 of the INSR pre-mRNA. Inhibits, together with HNRNPH1, insulin receptor (IR) pre-mRNA exon 11 inclusion in myoblast. Increases translation and controls the choice of translation initiation codon of CEBPB mRNA. Increases mRNA translation of CEBPB in aging liver. Increases translation of CDKN1A mRNA by antagonizing the repressive effect of CALR3. Mediates rapid cytoplasmic mRNA deadenylation. Recruits the deadenylase PARN to the poly(A) tail of EDEN-containing mRNAs to promote their deadenylation. Required for completion of spermatogenesis. Binds to (CUG)n triplet repeats in the 3'-UTR of transcripts such as DMPK and to Bruno response elements (BREs). Binds to muscle-specific splicing enhancer (MSE) intronic sites flanking the alternative exon 5 of TNNT2 pre-mRNA. Binds to AU-rich sequences (AREs or EDEN-like) localized in the 3'-UTR of JUN and FOS mRNAs. Binds to the IR RNA. Binds to the 5'-region of CDKN1A and CEBPB mRNAs. Binds with the 5'-region of CEBPB mRNA in aging liver. May be a specific regulator of miRNA biogenesis. Binds to primary microRNA pri-MIR140 and, with CELF2, negatively regulates the processing to mature miRNA.
-
基因功能參考文獻(xiàn):
- results underscore novel roles of CELF1 in melanoma, illustrating tumor type-restricted functions of mRNA binding proteins in cancer. PMID: 29269732
- These data present an 11-component genetic pathway, invisible to transcriptional profiling approaches, in which the CELF1 protein functions as a central node controlling translational activation of genes driving EMT and ultimately tumour progression. PMID: 27869122
- High CELF1 expression is associated with aberrant splicing in Type 1 diabetes. PMID: 28512194
- CELF1 globally regulates the alternative splicing. PMID: 28733224
- Findings indicate that IGF2R expression is controlled posttranscriptionally by two factors that associate with Igf2r mRNA and suggest that miR-195 and CUGBP1 dampen IGF signaling by inhibiting IGF2R translation. PMID: 28716948
- In the course of these studies, we found that RNA binding protein CUGBP1 is a new tumor suppressor protein which is reduced in all HBL samples. Therefore, we generated CUGBP1 KO mice and examined HBL signatures in the liver of these mice. Micro-array studies revealed that the HBL-specific molecular signature is developed in livers of CUGBP1 KO mice at very early ages PMID: 28535186
- Results show that CELF1 is a potential target of TUG1 interaction and could be negatively regulated by TUG1 RNA. PMID: 27485439
- CUG-binding protein 1 regulates HSC activation and liver fibrogenesis. PMID: 27853137
- High expression of CUGBP1 is associated with recurrence in lung adenocarcinoma. PMID: 26728670
- CUG-BP1 affected the calcium release activity in single myofibers and the extent of atrophy was significantly reduced upon gene silencing of CUG-BP1 in atrophic muscle. PMID: 26531141
- these data provided a comprehensive view of the CELF1 mRNA regulatory network in oral cancer PMID: 26498364
- forced expression of miR-214-3p enhances the sensitivity of esophageal cancer cells to cisplatin-induced apoptosis. This effect is abrogated with rescue expression of survivin or CUG-BP1 PMID: 26234674
- Expression of several genes within the CELF1 locus, including MTCH2, were highly correlated with one another and were associated with Alzheimer's disease status. PMID: 26919393
- CUGBP1 and HuR negate each other's effects in regulating E-cadherin translation by altering the recruitment of E-cadherin mRNA to PBs and play important roles in the regulation of intestinal barrier integrity. PMID: 26491048
- CUGBP1 promotes cell proliferation and suppresses apoptosis via down-regulating C-EBPalpha in human non-small cell lung cancers. PMID: 25701464
- The results indicate that the cellular level of miR-122 is determined by the balance between the opposing effects of GLD-2 and PARN/CUGBP1 on the metabolism of its 3'-terminus. PMID: 26130707
- CELF1 dysfunction in malignant T cells led to the up-regulation of a subset of GRE-containing transcripts that promote cell growth and down-regulation of another subset that suppress cell growth PMID: 26249002
- Celf1 has a role in vegetal RNA localization during Xenopus oogenesis PMID: 26164657
- These results demonstrate the importance of CUGBP1 in the biological and pathological functions of NSCLC and indicate its potential as a therapeutic target for NSCLC. PMID: 25619475
- The result is consistent with the hypothesis that MBNL proteins are trapped by expanded CUG repeats and inactivated in myotonic dystrophy type 1 (DM1) and that CELF1 is activated in DM1. PMID: 25403273
- CUGBP1 has a critical role in modulating cell growth and apoptosis PMID: 25077823
- the size and the number of colonies formed in gastric cancer MGC-803 cells were markedly reduced in the absence of CUGBP1 PMID: 24818870
- CUGBP1 seems to play a role in classic DM1 but not in DM2 PMID: 24376746
- The Alzheimer's disease single nucleotide polymorphism rs10838725 (pAD = 1.1 x 10(-08)) at the locus CELF1 is also genome-wide significant for obesity. PMID: 24788522
- Data suggest a model for RNA binding protein CELF1/CUGBP1-mediated regulation of alternative polyadenylation (APA). PMID: 25123787
- CUGBP1 was expressed in 85.7% hepatocellular carcinoma specimens compared with 50% in normal liver specimens. CUGBP1 silencing remarkably decreased the proliferation of HepG2 cells. PMID: 24502807
- High CUGBP1 expression is associated with non-small cell lung cancer. PMID: 23359188
- CELF1 depletion induces apoptosis in tumor cells, but not in normal cells. PMID: 23324604
- CUGBP1 represses occludin translation by increasing occludin mRNA recruitment to P-bodies. PMID: 23155001
- study suggests that regulation of CUGBP1 and MBNL1 is essential for accurate control of destabilization of a broad spectrum of mRNAs as well as of alternative splicing events PMID: 22355723
- The results suggest that CUG-BP1 binds to nucleotides 51-100 of the human albumin 3'UTR. In human cells CUG-BP1 binding may thus play a role in regulation of albumin expression and, additionally, it may have a function in post-transcriptional control in CHO cells. PMID: 22982313
- CUG-BP1 is overexpressed in oesophageal cancer cell lines and human oesophageal cancer specimens. CUG-BP1 associates with the 3'-untranslated region of survivin mRNA. PMID: 22646166
- CUG-binding protein represses translation of p27Kip1 mRNA through its internal ribosomal entry site PMID: 21508681
- CUGBP1 binding to certain GRE-containing target transcripts decreased following T cell activation through activation-dependent phosphorylation of CUGBP1. PMID: 22117072
- Stress granules component CUGBP1 was identified as a factor required for p21 mRNA stabilization. PMID: 21637851
- Data show that crystal structures of CUGBP1 RRM1 and tandem RRM1/2 domains bound to RNAs containing tandem UGU(U/G) elements. PMID: 20947024
- Overexpression of CUGBP1 in mouse skeletal muscle reproduces features of myotonic dystrophy type 1. PMID: 20603324
- identified 613 putative mRNA targets of CUGBP1 and found that the UGUUUGUUUGU GU-rich elements (GREs) sequence and a GU-repeat sequence were both highly enriched in the 3' UTRs of these targets PMID: 20547756
- These results strongly support a role for CUGBP1 up-regulation in myotonic dystrophy type 1 pathogenesis. PMID: 20051426
- CUGBP1 directly controls CD9 expression. PMID: 20227387
- CUG-BP and Xenopus EDEN-BP have very similar RNA-binding specificities; it is suggested that the CUG expansion associated with Type 1 myotonic dystrophy can affect the function of CUG-BP, leading to a trans-dominant effect on normal RNA processing PMID: 12799066
- Data show that epidermal growth factor receptor signaling results in phosphorylation of CUG-BP1, and leads to increased binding of CUG-BP1 to CCAAT/enhancer binding protein beta (C/EBP beta) mRNA and elevated expression of the C/EBPbeta LIP isoform. PMID: 15082764
- The results of this study suggest that the CUG expansion may bind to complementary sequences within the CUGBP1 mRNA and that this molecular interaction may affect CUGBP1 mRNA expression in DM1. PMID: 15099703
- CUG-BP, therefore, is the first RNA-binding protein shown to directly recruit a deadenylase to an RNA substrate.CUG-BP interacts with PARN in extracts by coimmunoprecipitation, and this interaction can be recapitulated using recombinant proteins PMID: 16601207
- coordinated physical and functional interactions between hnRNP H, CUG-BP1 and MBNL1 dictate IR splicing in normal and DM1 myoblasts PMID: 16946708
- transcription of Cugbp1 gene in muscle is regulated by myogenin and E proteins PMID: 17531403
- Insertional disruption of the CUGBP1 gene is associated with leukemogenesis PMID: 17854664
- Data show that expression of DMPK-CUG-repeat RNA results in hyperphosphorylation and stabilization of CUGBP1, and suggest that inappropriate activation of the PKC pathway contributes to the pathogenic effects of a noncoding RNA. PMID: 17936705
- CUG-BP1 specifically recognized UG repeats, probably through cooperative binding of RNA recognition motifs at both ends of the protein. PMID: 18039683
- These results demonstrate the dynamic behavior of CUGBP-1 during stress response and that the linker region, in concert with RRMs, plays a significant role in defining its subcellular localization and dynamics. PMID: 18164289
顯示更多
收起更多
-
亞細(xì)胞定位:Nucleus. Cytoplasm. Note=RNA-binding activity is detected in both nuclear and cytoplasmic compartments.
-
蛋白家族:CELF/BRUNOL family
-
組織特異性:Ubiquitous.
-
數(shù)據(jù)庫(kù)鏈接:
Most popular with customers
-
-
YWHAB Recombinant Monoclonal Antibody
Applications: ELISA, WB, IHC, IF, FC
Species Reactivity: Human, Mouse, Rat
-
Phospho-YAP1 (S127) Recombinant Monoclonal Antibody
Applications: ELISA, WB, IHC
Species Reactivity: Human
-
-
-
-
-